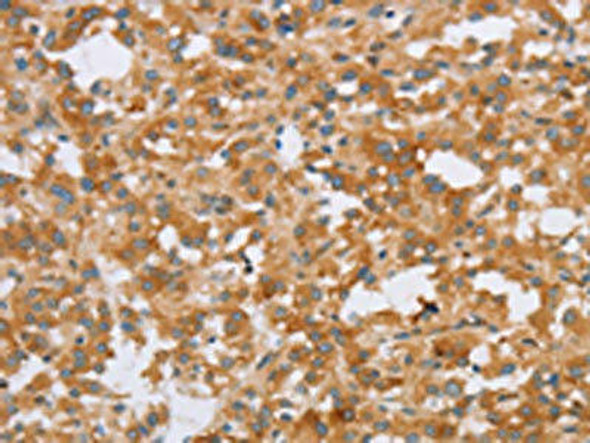
CRELD2 Antibody (PACO16073)

Antibodies
- Product
- Qty in Cart
- Quantity
- Price
- Subtotal
-

CXXC5 Antibody (PACO16092)
// system_update_altDatasheetsystem_update_altMSDSOverviewAntibody Name:CXXC5 Antibody (PACO16092)Antibody SKU:PACO16092Size:50ulHost Species:RabbitTested Applications:ELISA, WB, IHCRecommended Dilutions:ELISA:1:2000-1:5000, WB:1:200-1:1000,...Qty in Cart: 0Price:Subtotal: -

CTAGE5 Antibody (PACO16081)
// system_update_altDatasheetsystem_update_altMSDSOverviewAntibody Name:CTAGE5 Antibody (PACO16081)Antibody SKU:PACO16081Size:50ulHost Species:RabbitTested Applications:ELISA, WB, IHCRecommended Dilutions:ELISA:1:1000-1:2000, WB:1:200-1:1000,...Qty in Cart: 0Price:Subtotal: -

CRISP3 Antibody (PACO16075)
// system_update_altDatasheetsystem_update_altMSDSOverviewAntibody Name:CRISP3 Antibody (PACO16075)Antibody SKU:PACO16075Size:50ulHost Species:RabbitTested Applications:ELISA, IHCRecommended Dilutions:ELISA:1:2000-1:5000, IHC:1:50-1:200Species...Qty in Cart: 0Price:Subtotal: -

CRISP3 Antibody (PACO16074)
// system_update_altDatasheetsystem_update_altMSDSOverviewAntibody Name:CRISP3 Antibody (PACO16074)Antibody SKU:PACO16074Size:50ulHost Species:RabbitTested Applications:ELISA, IHCRecommended Dilutions:ELISA:1:2000-1:10000, IHC:1:100-1:300Species...Qty in Cart: 0Price:Subtotal: -
CRELD2 Antibody (PACO16073)
// system_update_altDatasheetsystem_update_altMSDSOverviewAntibody Name:CRELD2 Antibody (PACO16073)Antibody SKU:PACO16073Size:50ulHost Species:RabbitTested Applications:ELISA, WB, IHCRecommended Dilutions:ELISA:1:2000-1:5000, WB:1:500-1:2000,...Qty in Cart: 0Price:Subtotal: -

CRELD2 Antibody (PACO16072)
// system_update_altDatasheetsystem_update_altMSDSOverviewAntibody Name:CRELD2 Antibody (PACO16072)Antibody SKU:PACO16072Size:50ulHost Species:RabbitTested Applications:ELISA, WB, IHCRecommended Dilutions:ELISA:1:2000-1:5000, WB:1:500-1:2000,...Qty in Cart: 0Price:Subtotal: -

CLUAP1 Antibody (PACO16047)
// system_update_altDatasheetsystem_update_altMSDSOverviewAntibody Name:CLUAP1 Antibody (PACO16047)Antibody SKU:PACO16047Size:50ulHost Species:RabbitTested Applications:ELISA, WB, IHCRecommended Dilutions:ELISA:1:2000-1:5000, WB:1:500-1:2000,...Qty in Cart: 0Price:Subtotal: -

CLUAP1 Antibody (PACO16046)
// system_update_altDatasheetsystem_update_altMSDSOverviewAntibody Name:CLUAP1 Antibody (PACO16046)Antibody SKU:PACO16046Size:50ulHost Species:RabbitTested Applications:ELISA, IHCRecommended Dilutions:ELISA:1:2000-1:10000, IHC:1:100-1:300Species...Qty in Cart: 0Price:Subtotal: -

PLEKHO1 Antibody (PACO16039)
// system_update_altDatasheetsystem_update_altMSDSOverviewAntibody Name:PLEKHO1 Antibody (PACO16039)Antibody SKU:PACO16039Size:50ulHost Species:RabbitTested Applications:ELISA, IHCRecommended Dilutions:ELISA:1:1000-1:2000, IHC:1:25-1:100Species...Qty in Cart: 0Price:Subtotal: -

PLEKHO1 Antibody (PACO16038)
// system_update_altDatasheetsystem_update_altMSDSOverviewAntibody Name:PLEKHO1 Antibody (PACO16038)Antibody SKU:PACO16038Size:50ulHost Species:RabbitTested Applications:ELISA, WB, IHCRecommended Dilutions:ELISA:1:1000-1:2000, WB:1:200-1:1000,...Qty in Cart: 0Price:Subtotal: -

CGB Antibody (PACO16021)
// system_update_altDatasheetsystem_update_altMSDSOverviewAntibody Name:CGB Antibody (PACO16021)Antibody SKU:PACO16021Size:50ulHost Species:RabbitTested Applications:ELISA, WB, IHCRecommended Dilutions:ELISA:1:1000-1:2000, WB:1:200-1:1000,...Qty in Cart: 0Price:Subtotal: -

CGB Antibody (PACO16020)
// system_update_altDatasheetsystem_update_altMSDSOverviewAntibody Name:CGB Antibody (PACO16020)Antibody SKU:PACO16020Size:50ulHost Species:RabbitTested Applications:ELISA, IHCRecommended Dilutions:ELISA:1:2000-1:5000, IHC:1:50-1:200Species...Qty in Cart: 0Price:Subtotal:
